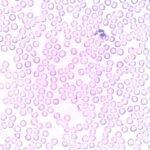
white-blood

Dark energy is a mysterious “something” that is causing unusual things to happen in the universe.
Among other things, dark energy seems to be accelerating the expansion of the universe and pulling galaxies away from each other.
In essence, dark energy makes up about 68 percent of everything in existence, yet no one knows what it actually is.
What is dark energy?
Well, first and foremost: it’s not “dark”. Dark energy is the name given by scientists to the unknown force causing unusual things to happen in the universe.
What those events are will be discussed below; for now, let’s focus on how dark energy was identified as a separate entity from mass and regular energy (which includes everything we know about, from solid objects to light).
In the 1930s, astronomer Edwin Hubble observed that galaxies were moving away from each other.
This observation was quickly interpreted as a confirmation of one of Albert Einstein’s predictions, namely that the universe is expanding.
However, if this expansion is constant and uniform throughout space (which is what Einstein believed), then over time the galaxies should all move away from us and eventually disappear from view.
This didn’t happen. By the 1970s it was clear that while most galaxies were indeed getting further apart, there were some exceptions.
Some galaxies appeared to be moving towards us, which couldn’t be explained by a uniform expansion.
In the late 1990s, astronomer Saul Perlmutter and two colleagues (Brian Schmidt and Adam G. Riess) identified this accelerating expansion as something distinct from mass-energy; they called it “dark energy” because it cannot be detected by traditional means.
The media has largely adopted ‘dark energy’ as an explanation for the accelerated expansion of the universe, without knowing what it is.
How is dark energy discovered?
Dark energy is discovered using a variety of techniques, but the most common one is to measure how fast galaxies are moving away from us.
This can be done by looking at their spectral lines – the different colors they emit – and seeing how they’ve shifted over time.
If the universe is expanding uniformly, then the spectral lines of all galaxies should be red-shifted to some extent.
However, if the universe is accelerating, then the spectral lines of galaxies in front will be blue-shifted, while those behinds will be red-shifted.
What Perlmutter and his colleagues did was to compare the magnitude of this shift (how much they were shifted) in very distant galaxies with those closest to us.
They found that the farther away a galaxy was, the more its spectral lines were shifted.
This indicated that the universe was not only expanding but doing so at an increasing rate. And hence, dark energy was born.
What could dark energy be?

There are a number of theories about what dark energy might be, but no one knows for sure.
Some scientists believe it could be made up of particles that are different from the ones we know about (including regular matter and light).
Others think it might be a property of space itself (i.e., a property of the vacuum).
And still, others believe it might be an entirely new type of energy that fills empty space and acts as its own anti-gravity force (an “antigravity field” like Star Trek: Voyager’s “dark matter”).
At this point, we don’t even know if dark energy is a particle or a property of space.
What we do know is that dark energy is causing the universe to accelerate in its expansion and that if this acceleration continues for long enough then it will cause all matter in the universe to separate from itself at some point in the distant future (when with nothing drawing us together we won’t be able to interact with each other).
- See also: How electricity was invented
- See also: What would happen if the speed of light was significantly slower
What causes dark energy?
We don’t know. What we do know is that it isn’t dark matter (which is required for galaxies to form) and it isn’t regular, baryonic matter either (which produces gravity).
It’s something entirely different from anything we’ve ever seen before.
And what about the “dark” part? Well, at this point it’s believed by some scientists that dark energy is a property of empty space itself, something that isn’t directly observable.
Other scientists believe that the “dark” part is because we don’t have any viable theories to explain it yet.
Either way, there are several pieces of indirect evidence suggesting that dark energy exists.
The most compelling of those is the fact that the expansion of the universe is accelerating.
What is the distinction between dark matter and dark energy?
Most astronomers now consider dark energy to be the name for whatever it is that’s causing the expansion of the universe to accelerate.
Dark matter, on the other hand, has always been thought of as the name for whatever it is that holds galaxies together.
Scientists believe that dark matter exists because they can see its effects on the rotation of galaxies. Galaxies spin faster than they should if they only had the matter we can see.
This is because there’s more gravity acting on them from the unseen, dark matter.
Conclusion
Scientists still have a lot to learn about dark energy.
What they do know, however, is that it’s something very strange and mysterious that seems to be affecting the expansion of the universe.
It’s causing the universe to accelerate in its expansion, and if this acceleration continues for long enough then it will cause all matter in the universe to separate from itself at some point in the distant future (when with nothing drawing us together we won’t be able to interact with each other).